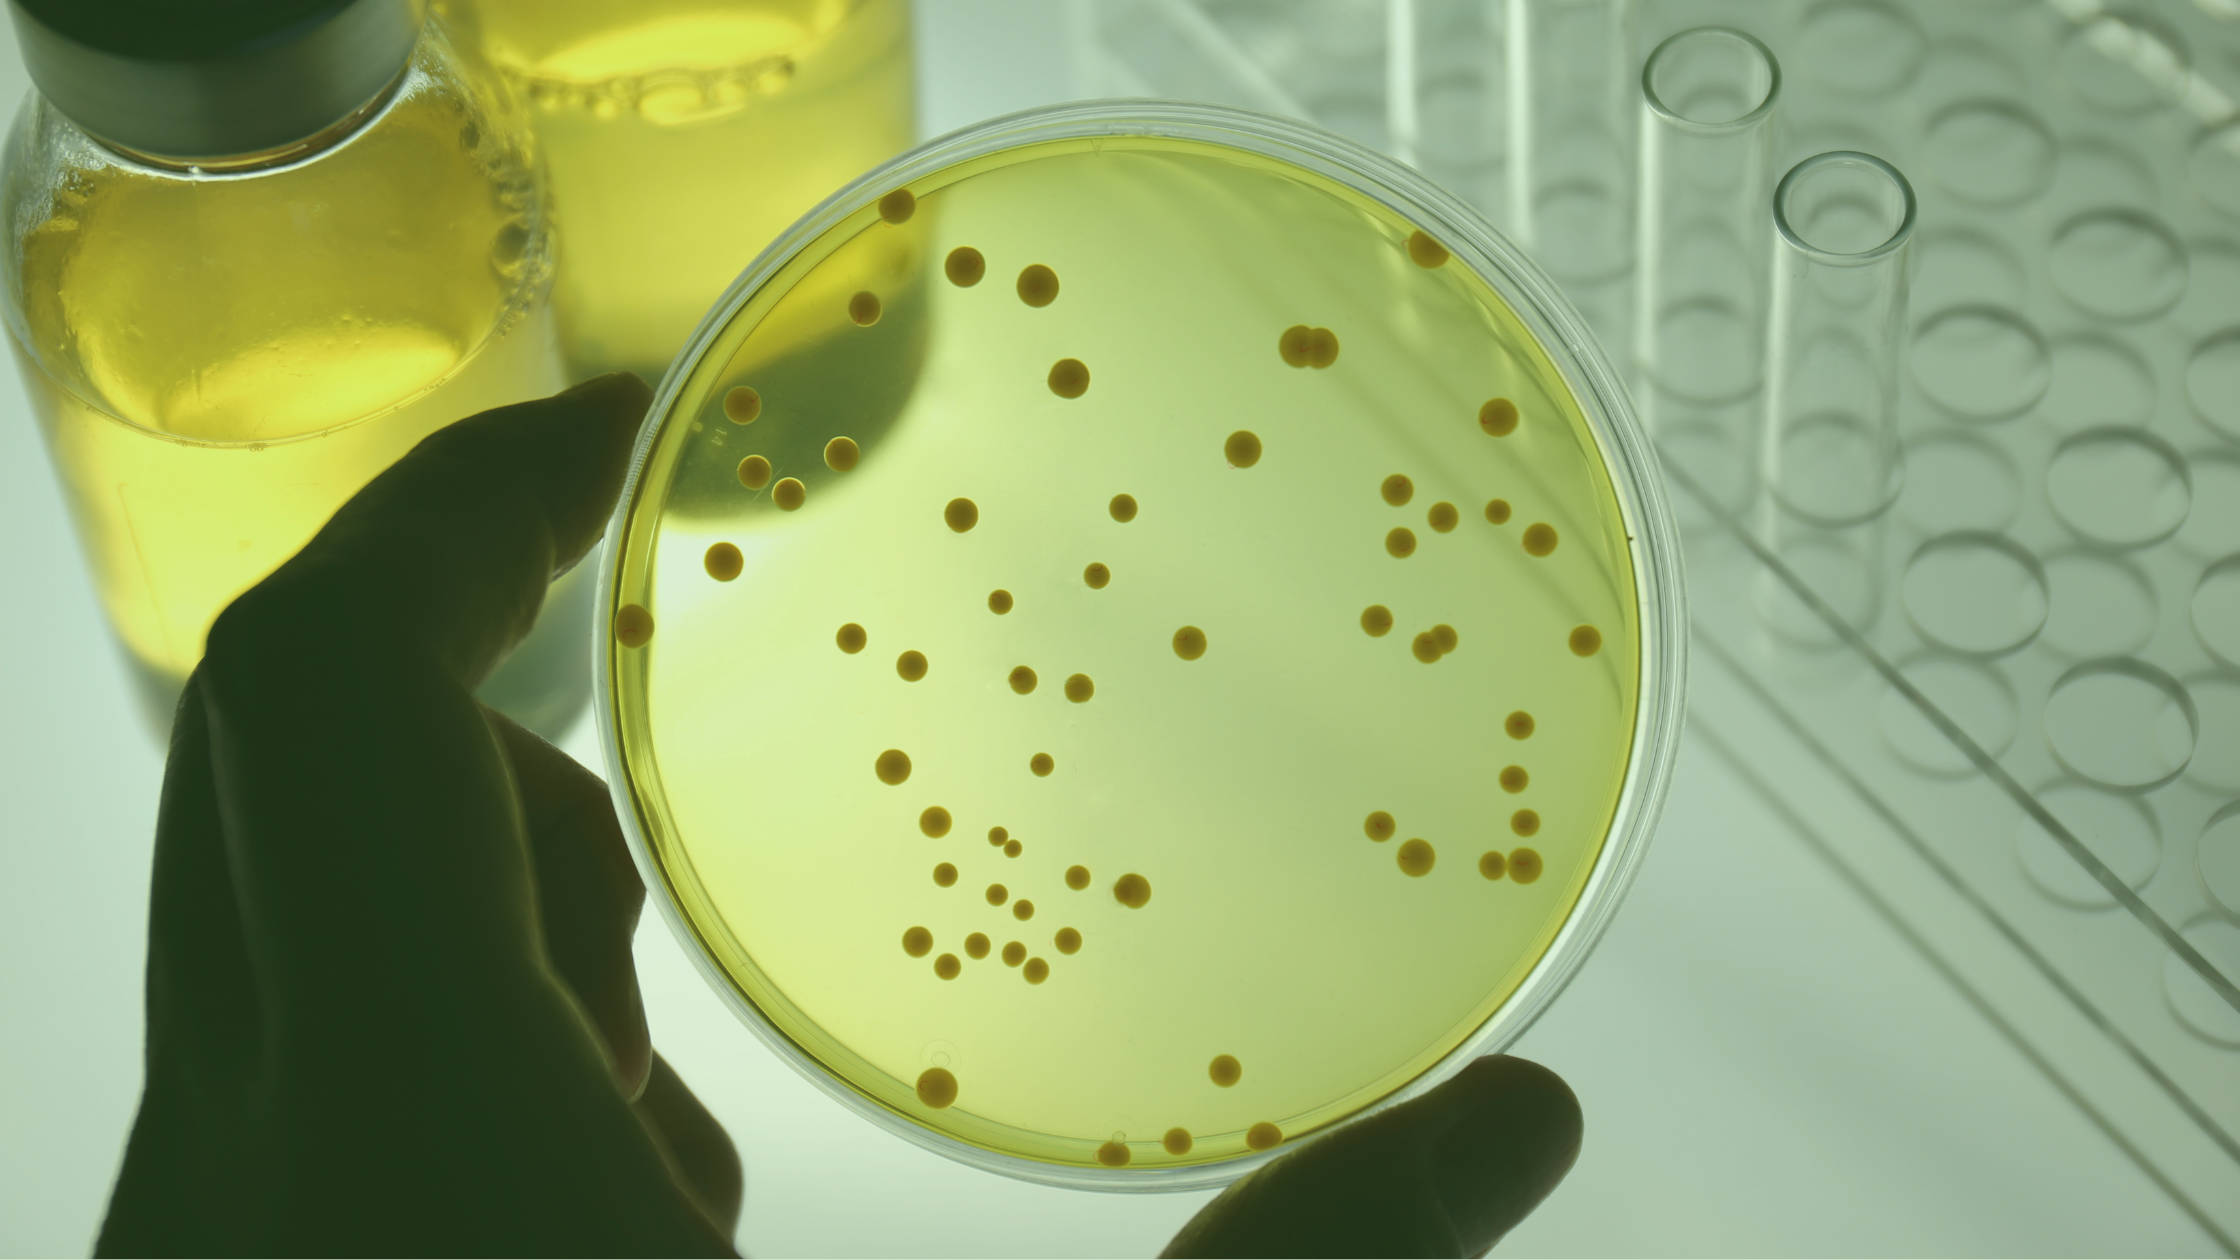

Q&A: Profundizamos en la Monitorización Microbiológica del Aire
En el ámbito de la monitorización ambiental, la toma de muestras microbiológicas en el aire desempeña un papel esencial. Un resultado habitual de la investigación en desviaciones microbiológicas es un fallo en el procedimiento de la propia toma de muestra.
En el artículo de hoy, repasamos conceptos básicos de la Monitorización Microbiológica del Aire (MMA), desde la terminología técnica hasta su aplicación práctica en diversos contextos.
Q&A: Monitorización Microbiológica del Aire
¿Por qué se realiza la prueba del contenido microbiano del aire?
El aire contiene microorganismos asociados a las partículas suspendidas en el aire. Estos microorganismos pueden contaminar productos farmacéuticos estériles, reducir la vida útil de alimentos y productos lácteos, infectar a pacientes en hospitales, contaminar sistemas HVAC con mohos en edificios, dañar antiguas obras de arte, contaminar teatros, oficinas, escuelas, trenes, etc.
¿Cuál es la diferencia entre un contador de partículas y un muestreador microbiológico de aire?
El contador de partículas mide rápidamente partículas no viables; el muestreador microbiológico de aire permite recoger partículas viables. El contador de partículas no puede distinguir entre partículas viables y no viables y no proporciona información sobre el contenido microbiológico del entorno. El contador de partículas es la respuesta para obtener resultados inmediatos de partículas no viables, mientras que el muestreador microbiológico de aire permite conocer el contenido microbiológico, después de la incubación de la muestra. Ambos métodos se utilizan, por lo tanto, para la Monitorización Ambiental del Aire.
¿Cuál es la definición de la MMA (Monitorización Microbiológica del Aire)?
La Monitorización Microbiológica del Aire (también llamada monitorización de viables en el Aire) tiene como objetivo capturar muestras de microorganismos (bacterias, mohos, levaduras) suspendidos en el aire en un medio nutriente, como una placa con medio de cultivo, para tras una posterior incubación de entre 2-3 días para bacterias y 3-6 para mohos y levaduras, visualizar su crecimiento.
¿Qué tipo de agar nutriente se utiliza para la MMA?
El Agar Soya Triptona (TSA) se utiliza típicamente para el recuento total de bacterias; el Agar Dextrosa Sabouraud (SDA) se utiliza para el crecimiento de mohos o levaduras. La cantidad mínima de agar en cada placa de Petri debe ser de 12-15 ml para la placa de contacto y de 25 a 35 ml para la placa de Petri estándar, que permita soportar la desecación que sufre la placa durante el tiempo de muestreo.

¿Cuál es el tiempo y la temperatura de incubación?
Las muestras bacterianas se incuban típicamente durante 48-72 horas a 30-37°C. Los mohos y las levaduras se incuban típicamente durante 4-6 días a 26-30°C.
¿Cuál es la diferencia entre la toma de muestras activa de aire microbiológica y los métodos pasivos (sedimentación)?
El muestreador activo de aire aspira un volumen conocido de aire que impacta a una velocidad constante en la superficie del medio agar, recogiendo partículas viables de diferentes tamaños. Con el método pasivo (sedimentación), las partículas viables caen naturalmente sobre la superficie de una placa de Petri abierta y su recolección varía según el flujo de aire, la humedad, la temperatura y el tamaño de los microorganismos. El método activo informa resultados cuantitativos en formato de CFU / 1000 litros de aire (=1 metro cúbico); el método de decantación informa los resultados que caen en la superficie abierta del agar en 4 horas. La cantidad de CFU recogida por el método activo es mucho mayor que con el método de sedimentación y los resultados cuantitativos se pueden aplicar a niveles de alerta y acción y alerta.
¿Por qué son importantes los datos de la Monitorización Ambiental para mejorar tu estrategia de control de la contaminación? Descúbrelo aquí
¿Cuál es la frecuencia de la Toma de Muestras Microbiana del Aire?
La frecuencia varía según la industria y la aplicación, pero en general se basa en análisis de riesgo o peligro y control de puntos críticos. Las empresas farmacéuticas que producen productos estériles deben seguir las indicaciones de las Autoridades Sanitarias y disponer de una CCS (Estrategia de Control de Contaminación) específica, siguiendo las premisas o requisitos del Anexo 1 de las GMP. La frecuencia es en continuo para áreas de fabricación en clase A y B.
¿Con qué frecuencia debe calibrarse un muestreador activo de aire microbiológico?
El tiempo está limitado a la frecuencia de uso, pero generalmente es cada 6-12 meses.
¿Debería controlarse la velocidad del flujo de aire de un muestreador de aire activo en el período entre la última y la nueva verificación de calibración?
Sí, es recomendable ya que si la calibración está fuera de límite durante la nueva calibración final, no se aceptarían los resultados del período anterior. Por lo tanto, una verificación a intervalos regulares utilizando un instrumento específico es una medida de seguridad y ahorro de coste y tiempo.

¿Cuál es el volumen correcto de aire que debe ser aspirado por un muestreador de aire activo?
Los resultados obtenidos siempre se refieren a un volumen aspirado de 1000 litros de aire (1 metro cúbico de aire). Para la toma de muestra, el volumen puede ajustarse al número esperado de microorganismos presentes en el entorno bajo control. El número de CFU/ placa debe ser fácil de contar (no más de aproximadamente 150 CFU. En zonas clasificadas A y B, puede ampliarse el volumen de aspiración al esperar 0 CFU en el aire, lo que facilita también aumentar el tiempo de muestreo para establecer una monitorización en continuo.
¿Por qué están disponibles cabezas de aspiración estériles para uso diario?
Los cabezales de aspiración del muestreador de aire suelen estar hechos de acero inoxidable y deben ser autoclavado antes de su uso, con la documentación correspondiente. La disponibilidad de cabezas de tecnopolímero estériles (“daily-shift”) utilizados durante un turno de trabajo completo evita todo el proceso de esterilización y elimina la posibilidad de falsos positivos.
¿Qué muestreador de aire activo debería usarse en sistemas de barrera como aisladores, RABS o cabinas de flujo laminar?
La unidad de comando debe estar fuera del aislador para ahorrar espacio interior, no romper el flujo laminar y minimizar el riesgo de contaminación microbiológica. Así, dentro del sistema de barrera se situaría únicamente el cabezal de aspiración o un una toma de aire tipo “embudo”.
¿Es necesaria una revalidación para la introducción de un nuevo muestreador de aire activo?
Sí. Se requiere una nueva validación. Hay disponible un protocolo específico.
¿Por qué usar un muestreador de aire activo con una aspiración de 200 litros por minuto en lugar de 100 litros por minuto?
El tiempo de muestreo del operador se reduce en un 50% y se realizan el doble de pruebas en comparación con 100 litros por minuto.
¿Por qué se sugiere adoptar un muestreador de aire activo con 2 o 3 cabezas de aspiración en lugar de solo una?
Hay varias ventajas:
- Uso de diferentes medios al mismo tiempo (por ejemplo: TSA para bacterias y SDA para mohos)
- Uso del mismo medio para obtener resultados estadísticos reales
- Uso del mismo medio que puede ser incubado a diferentes temperaturas, para bacterias y mohos
- Ahorro de tiempo del operador
- Aumentar el tiempo de monitorización, por ejemplo, pudiendo aplicar la monitorización en continuo durante el turno de producción.
- Reducción del riesgo de contaminación del operador porque se reduce la manipulación de las placas.
¿Es posible usar un muestreador de aire microbiológico activo en áreas con riesgo de explosión?
Sí. El modelo debe tener certificación oficial ATEX.


